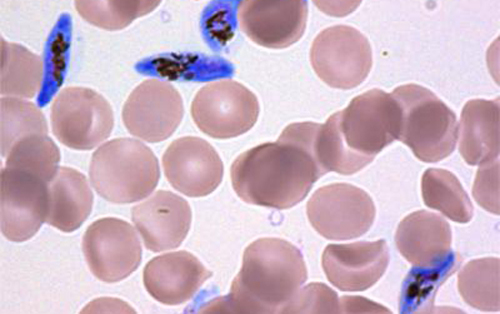

图中蓝色显示恶性疟原虫有性阶段-----配子体,红色圆形为红细胞。该图由宾州州立大学Manuel Llinas的实验室提供。
最近,两个独立研究小组发现了一种作为主要的基因调控因子调节疟原虫有性阶段雌雄细胞发育(这种有性阶段的疟原虫称为配子体)的调节性蛋白,该发现揭示了长久以来困扰疟原虫生物学界的一个秘密,其发现对人类健康有着十分重要的意义。这个蛋白,我们称之为AP2-G,是激活一系列启动配子体发育的基因所必须的,而配子体阶段是可以将疟原虫感染到蚊媒的唯一阶段。该研究同时为配子体发育调控机理和疟原虫传播疟疾机制的研究提供了重要线索。
虽然疟疾已在二十世纪五十年代几乎被清除了,但至今许多国家仍然面临着疟疾再次入侵的危险。根据美国疾病防控中心数据显示全球约有33亿人,占总人数的一半,包括106个国家和地区都面临着疟疾传播的危险。据世界卫生组织估计2010年全球有2.07亿疟疾感染病例和62.7万疟疾死亡病例,其中百分之七十七的死亡病例是五岁以下的儿童。
疟疾是由单细胞疟原虫感染引起的,为了存活和繁衍,这些疟原虫具有相当复杂的生活史。当人体被带有疟原虫的蚊子叮咬后感染,疟原虫首先进入并感染肝脏,随后进入人体红细胞,这个阶段是疾病发生和症状表现的时期,最后,疟原虫被叮咬过病人的蚊子传播到蚊体内,这是把疟原虫传播到其他人体所必须的阶段。上述所有感染阶段都是完成生活史所必须的。
令人惊讶的是,导致人体高强度周期性发烧的大多数感染红细胞的疟原虫不能传播到蚊子体内,只有有性阶段的配子体才可以完成此种传播。配子体是从感染红细胞的疟原虫在两天一循环中持续转化形成的,与大多数感染红细胞的疟原虫相比,它们具有非常不同细胞结构,以及不同的基因和蛋白表达谱。但是在每个循环中,只有少量感染红细胞的疟原虫可以转化为配子体,这是一种疟原虫生存的双刃模式:有利的是少量的配子体可以确保它们在干季能够生存,不利的是少量配子体可能会妨碍疟原虫的传播。
疟原虫如何“决定”转化成有性阶段的配子体一直是多年来困扰疟疾研究者的秘密。 宾夕法尼亚州立大学生物化学与分子生物学副教授Manuel Llinás说:“现在就有一个令人兴奋的潜在方法——通过阻止疟原虫完成生活史来有效阻断疟疾的传播。”
Llinás 是一个国际科学家团队的领导者,他们的研究成果将同Andy Waters (Glasgow 大学) 和Oliver Billker (Wellcome基金Sanger学院)的研究成果将于2014年2月23日一起在自然杂志的官方网站上发表。两篇论文阐述了AP2-G在两种高度分化的疟原虫(导致人类主要恶性疟疾的恶性疟原虫和常用于感染啮齿动物的伯氏疟原虫)中发挥几乎相同的功能。
“疟原虫只产生相对少量的有性阶段配子体这一弱点将成为一个诱人的防治疟疾的靶位。如果在人体内感染红细胞的疟原虫不能转化成配子体,那么就没有疟原虫有性阶段的配子体感染蚊子的胃,这样蚊子就不能感染其他人。” Llinás说道。
由Llinás主导的研究起初是由巴塞罗那国际健康研究中心Alfred Cortés研究组的实验开始的,他们发现从同一疟原虫株分离的不同克隆之间表达不同水平的AP2-G,而此蛋白的表达水平与有性阶段配子体生成的水平呈正相关。
“这个结果令人惊讶,因为我们发现不同疟原虫细胞系转化出的有性阶段配子体水平差别相当大。” Llinás说。其中一个细胞系可转化出的配子体水平是其它细胞系的十倍以上,而大多数细胞系只转化少量配子体,甚至有些细胞系根本不能转化任何配子体。随后的实验显示每一个疟原虫克隆转化配子体的真实水平与AP2-G蛋白的表达水平呈正相关。“我们的结果显示了ap2-g基因的表达与配子体转化率有完美的正相关性。” Llinás说道。

图中显示一个按蚊经皮肤吸血。如果被吸入的血液含有有性阶段的配子体,这些疟原虫会在蚊体内发育,数天后,感染疟原虫的蚊子通过再次叮咬,就会把疟原虫传播给其他人。该图源自美国疾病防控中心。
因为这些疟原虫克隆具有同样的DNA,或者说同样的基因组成,但是它们却转化出明显不同水平的有性阶段的疟原虫。Llinás说:“因此我们猜想是某种基因以外的因子——不是因为基因突变——来控制有性阶段的发育。”
研究结果提示这种现象不是由于疟原虫基因本身,而是虫体之间的“表观遗传学”的区别造成的。“实际上,” Llinás说,“以往的研究已发现ap2-g基因的表达通过组蛋白的修饰等表观遗传性方式而受到抑制。”Cortés补充道:“多年来我们己经发现疟原虫应用表观遗传行的机制逃避人体宿主免疫应答。现在我们知道这种机制也在控制着包括疟原虫有性阶段的转化在内的其它重要的疟原虫生物过程。”
当科学家发现了一个像AP2-G这样调控着一种生物过程的蛋白后,下一个典型问题是:有哪些其它蛋白调节这个调控蛋白?“我们的发现有一个有趣的结果,那就是我们不需要通过上游调控因子来调节AP2-G的表达,相反,AP2-G可以通过表观遗传性机制激活,这就为有性阶段配子体的低水平转化提供了合理的解释。” Cortés补充道。
由伦敦卫生和热带病医学院和Wellcome基金Sanger学院的David Baker, Taane Clark 及其同事们所进行的一项独立研究中分析了两个实验室恶性疟虫株全基因组序列,他们惊奇的发现这两株根本不能转化配子体的疟原虫均含有突变的无功能的ap2-g基因。
David Baker说:“我的实验室在超过二十年的时间里一直对控制疟原虫有性阶段转化的机制感兴趣,现在终于发现了受表观遗传性控制的ap2-g与之相关。”同时,Waters 和 Billker研究组用一年的时间筛选出不能转化配子体的鼠疟原虫,用新一代测序方法发现导致这种现象的可能的突变,同样的,他们也发现一个同样的嫌疑犯——那就是编码AP2-G蛋白的ap2-g基因。
为了进一步确认这些发现,这两个研究小组通过把ap2-g基因从疟原虫基因组中敲除从而使ap2-g基因失去功能,而敲除了ap2-g基因的疟原虫确实失去了产生有性阶段疟原虫的能力。此外,当突变的ap2-g基因被修复后,鼠疟原虫又可重新产生配子体。
以上实验结果显示有性阶段的疟原虫只有在AP2-G正确表达的条件下才能产生。“我们的研究明确的证实了转录因子AP2-G是疟原虫在红细胞内由无性阶段转化为有性阶段过程中的关键因子。” Llinás说。
研究者们一致认为这些发现是非常令人兴奋的。他们将可以通过实验方法来调控AP2-G蛋白的表达,并以此来调控疟原虫转化到有性阶段的能力。“这项研究打来了一个窗口¬¬------通过筛选有效抑制疟原虫转化为有性阶段的药物可以阻断疟疾的传播。” Waters说。
Billker 补充道:“AP2-G功能的发现给我们提供了一个新的起点---探索疟原虫内的蛋白如何调控疟原虫复杂的生活史。这样或许会使我们在实验室内可以更好的控制疟原虫的发育。”
本研究结果也可以促进大量培养有性阶段的疟原虫,这样将会有助于有性阶段疟原虫疫苗的研发。这类疫苗将会帮助被感染的人获得免疫力,从而防止疟原虫传播到蚊媒。“利用新一代实验技术我们可以乐观的估计不久的将来——或许在近五年——会出现更多的与疟疾防治相关的新发现。” Llinás说。
